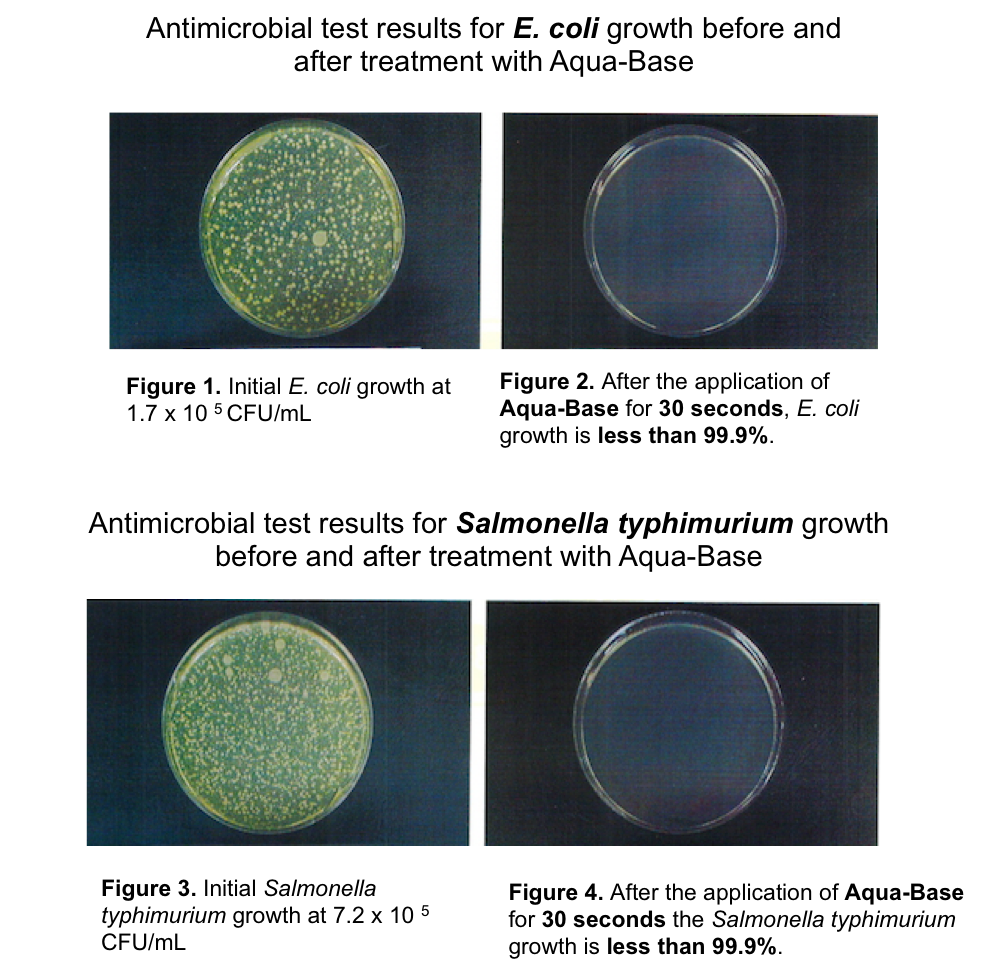

1
/
of
3
BB Aqua-Base Sanitising Surface Spray
BB Aqua-Base Sanitising Surface Spray
Regular price
$14.00 AUD
Regular price
Sale price
$14.00 AUD
Unit price
/
per
Tax included.
Shipping calculated at checkout.
Couldn't load pickup availability
SANITISING SURFACE SPRAY
AQUA-BASE is a natural antibacterial spray that uses strong alkaline reduced water (pH 12.5) made by a process called electrolysis.
The high pH level of the water makes it very difficult for common household bacteria such as Salmonella and E. coli to survive.
This product has been scientifically tested for bacterial growth and dermatology tested. Safe on skin.
Use as a multi-purpose surface sanitiser, de-greaser or deodoriser.
This is definitely the future of green sanitising and cleaning!
- Laboratory proven to kill 99.9% of common household bacteria such as Salmonella and E.coli (see test results attached)
- It contains NOTHING but 99.9% alkaline water (pH 12.5). Bacteria cannot survive in pH 12.5 environment.
-
Kills germs, sanitises, de-greases and deodorises all surfaces after 30 seconds of spraying.
Suitable to use on: - Kitchen benches and all high contact areas such as fridge doors, handles etc.
- Safe to use on chopping boards, kitchen sponges, make-up sponges, tea towels etc
- Bathroom areas to kill germs on toilet seats, taps and all high contact areas.
- All appliances and to de-grease stove tops and range hoods.
- Glass and mirrors (streak free)
- Safe to use on children’s toys
- To deodorise textiles, pet beds, clothing, shoes etc.
- Eco friendly antibacterial option.
- Non-toxic.
- Safe to use on skin.
- $15 Flat Rate Standard Shipping
- $20 Flat Rate Express Shipping